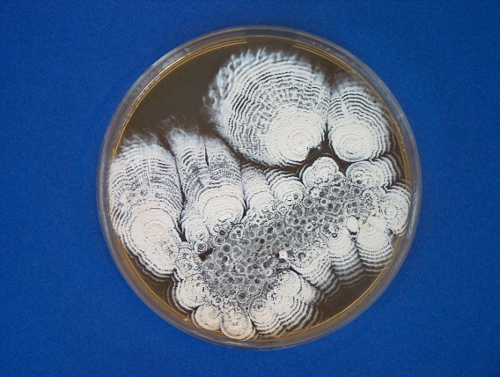

Pictures
Mycoparasitism of Trichoderma harzianum on Sclerotinia sclerotiorum
Mycoparasitism of Trichoderma harzianum on Rhizoctonia solani
No mycoparasitism (negative) of Trichoderma harzianum on Fusarium oxysporum f.sp. dianthi
Fungal colonies from soil on PDA supplemented with doxycycline hyclate
Thermophilic actinomycetes

Streptomyces albidoflavus

Trichoderma atroviride

Trichoderma harzianum

Mucor sp.
Solid state fermentation (SSF) in Erlenmeyer-flask

Solid state fermentation (SSF) in Erlenmeyer-flask
Solid state fermentation (SSF) in Erlenmeyer-flask
Solid state fermentation (SSF) in Erlenmeyer-flask

Growth of Trichoderma virens on wheat straw in solid state fermentation (SSF)
Growth of Trichoderma asperellum on wheat straw in solid state fermentation (SSF)
Growth of Streptomyces mobaraense on rice in solid state fermentation (production of transglutaminase)

Silver nanoparticles produced from silver nitrate by Chaetomium globosum OKI 270 nitrate reductase enzyme
Streptomyces paucisporogenes
Rhodococcus equi
Epicoccum nigrum
Pseudonocardia compacta
Penicillium claviforme
Geotrichum candidum
Szakács György, Szakács György, Szakács György, Szakács György, Szakács György, Szakács György, Szakács György, Szakács György, Szakács György, Szakács György, Szakács György, Szakács György, Szakács György, Szakács György, Szakács György, Szakács György, Szakács György, Szakács György, Szakács György, Szakács György, Szakács György, Szakács György, Szakács György, Szakács György, Szakács György, Szakács György, Szakács György, Szakács György, Szakács György, Szakács György, Szakács György, Szakács György, Szakács György, Szakács György, Szakács György, Szakács György, Szakács György, Szakács György, Szakács György, Szakács György, Szakács György, Szakács György, Szakács György, Szakács György, Szakács György, Szakács György, Szakács György, Szakács György, Szakács György, Szakács György, Szakács György, Szakács György, Szakács György, Szakács György, Szakács György, szakács györgy, Szakács György, dr szakács györgy, DR. Szakács György